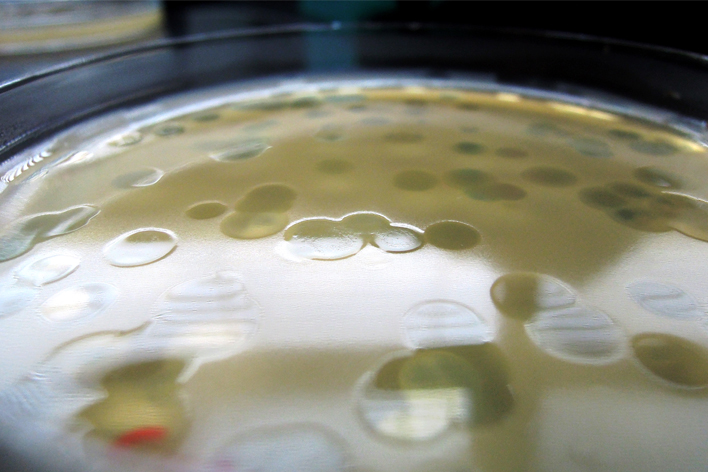
708x472_3

El programa de Magíster en Ciencias Microbiología dictado por el Instituto de Biología de la Pontificia Universidad Católica de Valparaíso es un programa de carácter académico destinado a fortalecer la investigación en el área.
Está destinado fundamentalmente a estudiantes del área de las Ciencias Biológicas o carreras afines que quieran fortalecer sus habilidades de Investigación en todas las áreas de las Ciencias Microbiológicas:
El programa tiene una duración de cuatro semestres académicos. El plazo máximo para la obtención del grado es de cinco semestres.

Podrán postular a este programa las personas que estén en posesión de un título o grado académico universitario en el área de la Biología, Bioquímica, Ciencias Biomédicas o carrera afín. El grado académico deberá ser, al menos, equivalente al de licenciatura y el título profesional deberá acreditar un nivel y contenido de estudios equivalentes a los necesarios para obtener el grado de licenciado, todo ello de conformidad con las normas legales del Ministerio de Educación.
El llamado para la postulación de nuevos estudiantes será anual (entre octubre a diciembre, para ingreso en marzo del año siguiente) y se informará a través de todas las plataformas que cuente el Instituto de Biología y la Universidad.
Los postulantes además rinden una prueba de selección y se someten a una entrevista personal. El proceso de selección de los postulantes será realizado por un Comité de Selección conformado por miembros del Claustro Académico.
| Semestre 1 | Semestre 2 | Semestre 3 | Semestre 4 |
|---|---|---|---|
| Ciencias Microbiológicas Avanzadas | Proyecto de Tesis | Tesis | Tesis |
| Métodos en Ciencias Microbiológicas | Optativo | ||
| Bioinformática |
| Semestre 1 |
|---|
| Ciencias Microbiológicas Avanzadas |
| Métodos en Ciencias Microbiológicas |
| Bioinformática |
| Semestre 2 |
| Proyecto de Tesis |
| Optativo |
| Semestre 3 |
| Tesis |
| Semestre 4 |
| Tesis |